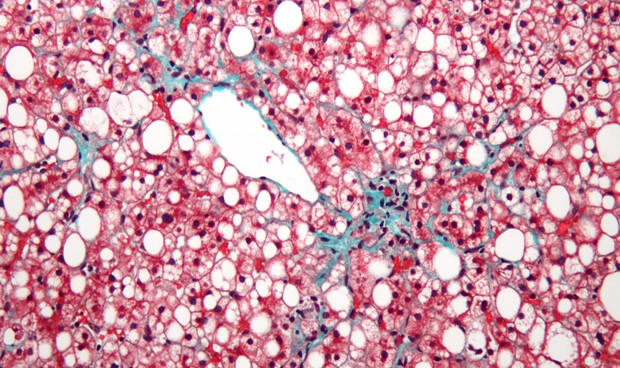
Uno de cada 5 casos de esteatosis hepática no alcohólica deriva en cirrosis

La
esteatosis hepática
no alcohólica es el subtipo inflamatorio de la enfermedad del hígado graso no alcohólico y se asocia con la progresión de la enfermedad, el desarrollo de cirrosis en el 20 por ciento de los casos y la necesidad de trasplante de hígado. Pero "a pesar de su importancia
, no está reconocida en la práctica clínica", según una revisión publicada en
JAMA.
La esteatosis hepática está fuertemente
asociada con la obesidad, la dislipidemia, la diabetes tipo 2 y el síndrome metabólico. Aunque existen varias pruebas no invasivas y sistemas de puntuación para caracterizar la enfermedad del hígado graso no alcohólico,
la biopsia hepática es el único método aceptado para el diagnóstico según señalan los autores.
|
"La cirugía bariátrica puede estar indicada para lograr y mantener el grado necesario de pérdida de peso"
|
Además, indican que "la Administración de Alimentos y Medicamentos de EEUU (FDA, por sus siglas en inlgés)
no aprueba ninguna terapia específica para esta enfermedad. La modificación del estilo de vida es el pilar del tratamiento, incluidos los cambios en la dieta y el ejercicio, con el objetivo principal de perder peso. La mejora sustancial de los resultados histológicos, incluida la fibrosis, se correlaciona directamente con el aumento de la pérdida de peso", aseguran.
"En algunos casos,
la cirugía bariátrica puede estar indicada para lograr y mantener el grado necesario de pérdida de peso requerido para el efecto terapéutico. Se estima que el 20 por ciento de los pacientes con esteatohepatitis desarrollarán cirrosis, y se prevé que se convierta en la principal indicación para los trasplantes de hígado en los EEUU!, añaden.
La tasa de mortalidad entre los pacientes con esteatohepatitis es sustancialmente más alta que la población general o los pacientes sin este subtipo inflamatorio de enfermedad del hígado graso no alcohólico, con una tasa anual de mortalidad por todas las causas de 25,56 por 1000 personas al año y una tasa de mortalidad específica del hígado de 11,77 por 1000 personas años.
"La identificación temprana y el tratamiento dirigido de pacientes con esteatosis hepática no alcohólica son necesarios para mejorar los resultados de los pacientes, incluida la orientación de los pacientes hacia una
modificación intensiva del estilo de vida para promover la pérdida de peso y la derivación para cirugía bariátrica según lo indicado para el manejo de la obesidad y la enfermedad metabólica", concluyen los autores.
Las informaciones publicadas en Redacción Médica contienen afirmaciones, datos y declaraciones procedentes de instituciones oficiales y profesionales sanitarios. No obstante, ante cualquier duda relacionada con su salud, consulte con su especialista sanitario correspondiente.